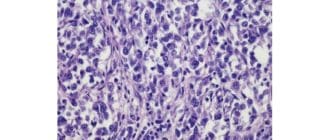

整形手術の分野では、生殖器の美容整形手術は、女性と男性の両方のための蒸気を拾っています。この記事では、生殖器の美容整形手術を検討する際に、一般的な性的欲求や性的欲求を追加することができるかどうか、また何を念頭に置くべきか […]
シラミは、髪や頭皮に生息するゴマの大きさの小さな昆虫です。彼らは人間の血液を食べ、体から落ちるとすぐに死ぬ。しかし、シラミを排除する最も効果的な方法は何ですか? シラミは、人から人へと伝染性が高く、少数の卵でさえも感染を […]
アメリカ心理学会(APA)は、メディアの少女や若い女性の性的イメージの拡散が自分自身にイメージや発達を害していることを示唆している。 女子の性的虐待に関するAPAタスクフォースは、テレビ、音楽ビデオ、雑誌、ビデオゲーム、 […]
成人期の水痘ウイルスの再活性化による神経発疹である帯状疱疹は、脳卒中や他の血栓症の独立した危険因子であり、その関連性が確認された最大の研究である。 研究者らは、米国神経学アカデミーのジャーナルに彼らの発見を発表し、研究者 […]
ダニは、クモのような生き物の同じ家族の中にある小さな8脚のバグです。刻みは、ライフサイクルを完了するために血液を吸う。 ティックは体のどこにでもかみ合うことができます。彼らはしばしば、鼠蹊部や脇の下など身体の湿った部分に […]
血糖値を管理することは、糖尿病でうまく生き、より深刻な健康上の問題を回避するための鍵です。これは、糖尿病の人にとって、健康的な食生活が続くことが不可欠であることを意味します。 糖尿病の食事プランが役立ちます。良い食事プラ […]
蚊は小さな飛行昆虫です。女性の蚊には長いピアスマウスピースがあり、彼らは彼らの血を消費するために宿主の皮膚を突き刺す。 血液は卵のためのタンパク質源として働く。オスの蚊は、血液を必要としないので噛む能力がありません。 蚊 […]
糖尿病は、体内の血糖値やインスリン値に影響を及ぼす広範な障害です。糖尿病の長期的な結果や合併症を管理することは、病気そのものと同様に大きな課題です。 糖尿病には主に2つのタイプがあります。 1型糖尿病は、膵臓がインスリン […]
臼歯は皮膚の小さな病変です。それらはメラノサイトの集合体である。メラノサイトは、メラニン産生細胞である。メラニンは肌に色を与える色素です。 臼歯は通常茶色がかっていますが、一部ははるかに濃く、その他は肌色です。彼らは粗く […]
誰もが、特に十代の若者の間で、彼らの正統な性的神話を聞いた。残念なことに、いくつかの神話は大人になっても持続し、私たちの性生活に関係する方法に影響を及ぼします。ここでは、性に関する最も広範な誤解のいくつかを暴露しています […]
漿液腫は、組織が除去された身体の場所に体液が蓄積することです。彼らはしばしば手術の合併症として発生するが、けがの後にも発症する可能性がある。 血清腫は、乳癌を治療する手術後に女性の乳房領域で最も一般的に見られる。血清腫を […]
大部分の医療従事者は大腸癌のスクリーニングに大腸内視鏡検査の使用を推奨しています。残念なことに、この手順はコストがかかり、侵襲性を感じる可能性があります。 この記事では、大腸内視鏡検査に躊躇している人が検討したい大腸癌ス […]
チェリー血管腫は、小さな血管や毛細血管でできた胞子状の皮膚の成長です。これは、血管腫の最も一般的なタイプであり、毛細血管の過増殖から生じる良性腫瘍である。 子供たちがこれらの非癌病変を発症することはまれです。チェリー血管 […]
冬はよく、本当に私たちにあります。多くの地域では、これは悲惨な天気、日光や暗い日を意味します。私たちは暖かさと日差しがいっぱいになることを大いに望んでいますが、私たちの多くは季節の変化に適応します。しかし、他の人にとって […]
軟部組織肉腫は、身体系のいずれかを接続し、支持し、または取り囲む組織に影響を及ぼす腫瘍である。肉腫は骨、皮膚、および他の軟組織に影響を及ぼす。このページは特に軟組織肉腫について説明しています。 肉腫は、結合組織に影響を及 […]
初めて、H7N9鳥インフルエンザウイルスの包括的な遺伝子解析が中国の科学者によって行われました。この発見は、ウイルスの起源および進化の歴史を包含する。 新型鳥インフルエンザA H7N9ウイルスの最初の症例が2013年3月 […]
強引症は、指の皮膚の締め付けと肥厚である。それは、指を内側にカールさせ、手を爪状にする可能性があります。 全身性強皮症は、米国では50万人未満の人々に影響を及ぼす自己免疫疾患および関節炎のまれな形態である強引症を引き起こ […]
人間のテロメア(染色体を劣化から守るキャップ)の短縮は、高齢化や病気の原因となっています。現在、スタンフォード大学医学部の研究者らは、これらのテロメアを長くする方法を見出し、多くの加齢および遺伝的状態のための新たな治療へ […]
老人性紫斑病は、ベイトマンの紫斑または光線性紫斑病としても知られており、一般に老化した皮膚に影響を与える病気です。 公正な皮を剥がした高齢者は、この状態を発症する可能性がより高い。それは、暴露された皮膚上に、通常は腕と手 […]
出版された新しい研究は、統合失調症の将来の治療における新規タンパク質の潜在的役割を調べた。特定のタンパク質の分解を妨害することが鍵となる可能性があります。 統合失調症は、生涯にわたって100人中1人に影響を及ぼす非常に破 […]
壊死性筋膜炎の主要な原因である細菌、または肉食病は、免疫系がそれを攻撃するのを止める神経系を得ることによって、広範囲にわたる致命的な感染を引き起こす。 マサチューセッツ州ボストンのハーバード大学医学部の科学者たちが率いる […]